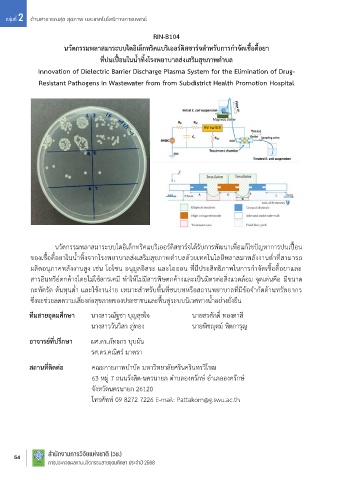

Page 56 - Expo68
P. 56
กลุ่มที่ 2 ด้านสาธารณสุข สุขภาพ และเทคโนโลยีทางการแพทย์
RIN-B104 RIN-B105
ั
ิ
นวัตกรรมพลาสมาระบบไดอิเล็กทริคแบริเออรดิสชาร์จส าหรับการก าจัดเชื้อดื้อยา เซนเซอรไทรโบอิเล็กทริกไฮโดรเจลส าหรบตดตามปริมาณแลคเตทจากเหงื่อ เพื่อเฝาระวังอาการกล้ามเนื้ออ่อนล้า
์
์
้
ที่ปนเปื้อนในน้ าทิ้งโรงพยาบาลส่งเสริมสุขภาพต าบล Hydrogel Triboelectric Sensor for Sweat Lactate Level Tracking to Monitor Muscle Fatigue
Innovation of Dielectric Barrier Discharge Plasma System for the Elimination of Drug-
Resistant Pathogens in Wastewater from from Subdistrict Health Promotion Hospital
่
ั
ั
ิ
ื
นวตกรรมไฮโดรเจลไทรโบอเล็กทริกเซนเซอร์ (LH-TES) ส ำหรบติดตำมปริมำณแลคเตทในเหงอ
ได้มีกำรพัฒนำเพื่อติดตำมระดับแลคเตทที่เป็นสำรส ำคัญของอำกำรกล้ำมเนื้ออ่อนล้ำ ด้วยกลไกกำรสัมผัส
และกำรไหลของไอออนในไฮโดรเจลเมอไม่มและมแลคเตทในระดับต่ำง ๆ โดยไฮโดรเจลจะถกทำใหไวตอสำร
่
ี
่
ี
ู
้
ื
แลคเตทด้วยเอนไซม์ที่ทำหน้ำที่ออกซิไดซ์แลคเตท แล้วได้ผลิตภัณฑ์ H2O2 ซึ่งปริมำณของ H2O2 จะแปรผันตรง
กับค่ำสัญญำณไฟฟ้ำที่ได้ ท ำให้อุปกรณ์นี้สำมำรถบอกปริมำณแลคเตทได้ทดแทนกำรตรวจเลือด
ในโรงพยำบำล เหมำะส ำหรับนักกีฬำและผู้ที่ต้องกำรติดตำมสมรรถภำพร่ำงกำยหรือสุขภำพอย่ำงต่อเนื่อง
นวัตกรรมพลำสมำระบบไดอิเล็กทริคแบริเออร์ดิสชำร์จได้รับกำรพัฒนำเพื่อแก้ไขปัญหำกำรปนเปื้อน ทีมสายอุดมศึกษา นำงสำวกมลวรรณ มิ่งขวัญ
ิ
ื
ื
้
ิ
ของเช้อด้อยำในนำทงจำกโรงพยำบำลส่งเสรมสุขภำพต ำบลด้วยเทคโนโลยีพลำสมำพลังงำนต่ ำที่สำมำรถ นำงสำวนันทิชำ บำนใจ
้
่
ี
ี
้
ื
ั
ิ
ิ
ู
ุ
่
ุ
ผลิตอนภำคพลังงำนสูง เชน โอโซน อนมลอสระ และไอออน ทมประสิทธภำพในกำรกำจดเชอดื้อยำและ อาจารย์ที่ปรึกษา ผศ.ดร.ฐิติรัตน์ จรุญสุข
้
สำรอินทรีย์ตกค้ำงโดยไม่ใชสำรเคมี ท ำให้ไม่มีสำรพิษตกค้ำงและเป็นมิตรต่อสิ่งแวดล้อม จุดเด่นคือ มีขนำด สถานที่ติดต่อ
้
กะทัดรัด ต้นทุนต่ ำ และใชงำนงำย เหมำะส ำหรับพื้นที่ชนบทหรือสถำนพยำบำลที่มีข้อจ ำกัดด้ำนทรัพยำกร คณะวิทยำศำสตร์ มหำวิทยำลัยศรีนครินทรวิโรฒ
่
ซึ่งจะช่วยลดควำมเสี่ยงต่อสุขภำพของประชำชนและฟื้นฟูระบบนิเวศทำงน้ ำอย่ำงยั่งยืน 114 สุขุมวิท 23 แขวงคลองเตยเหนือ เขตวัฒนำ กรุงเทพฯ 10110
โทรศัพท์ 09 8519 1094 E-mail: kamonwan.mingkhwan@g.swu.ac.th
ทีมสายอุดมศึกษา นำงสำวณัฐชำ บุญสุขใจ นำยสรศักดิ์ ทองตำสี
นำงสำววันวิสำ ภู่ทอง นำยพิชญุตม์ หิตกำรุญ
อาจารย์ที่ปรึกษา ผศ.ดร.ภัทธกร บุบผัน
รศ.ดร.คณิศร์ มำตรำ
สถานที่ติดต่อ คณะกำยภำพบ ำบัด มหำวิทยำลัยศรีนครินทรวิโรฒ
63 หมู่ 7 ถนนรังสิต-นครนำยก ต ำบลองครักษ์ อ ำเภอองครักษ์
จังหวัดนครนำยก 26120
โทรศัพท์ 09 8272 7226 E-mail: Pattakorn@g.swu.ac.th
48 ส�นักง�นก�รวจยแหงช�ติ (วช.) ส ำนักงำนกำรวิจัยแห่งชำติ (วช.) ส ำนักงำนกำรวิจัยแห่งชำติ (วช.) 49
่
ั
ิ
ำ
54
ั
การประกวดผลงานนวตกรรมสายอดมศกษา ประจาปี 2568
ุ
ำ
ึ